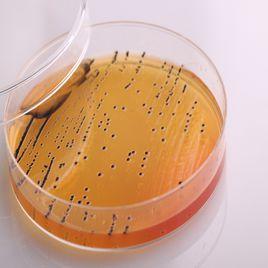
沙門菌屬 沙門菌屬

(一)沙門菌屬的生物學特性
1.形態與染色:本屬菌為(0.7~1.5)μm×(2.0~5.0)μm,無芽胞,無莢膜的革蘭陰性直桿菌。除雞沙門菌外都有周身鞭毛,能運動,多數有菌毛。
2.培養特性:營養要求不高,在普通瓊脂培養上即能生長,在液體培養基中呈均勻混濁。在SS瓊脂和麥康凱瓊脂培養基上35℃~37℃24h可形成直徑約2~4mm的透明或半透明菌落,對膽鹽耐受。產H2S者在SS瓊脂上形成黑色中心。
3.生化反應:除亞利桑那菌外均不能發酵乳糖,大多數IMViC試驗為-+-+,KIA:K/A、產氣+/-、H2S+/-,MIU:動力+、吲哚-、脲酶-.
4.抗原結構:主要由0抗原和H抗原組成,部分菌株有類似大腸桿菌K抗原的表面抗原,與細菌的毒力有關,故稱Vi抗原。
(1)0抗原:即菌體抗原。沙門菌屬的菌體抗原有58種,以阿拉伯數字依次標記:根據沙門菌有共同的O抗原這一特點,分類學者將有共同抗原的細菌歸為一組,這就使沙門菌分成42個群(或組)。即A、B、C……Z和O16~O67群。每群都有群特異性抗原,如A群O2、B群04、D群O9等。
(2)H抗原:即鞭毛抗原。H抗原是定型的依據。
沙門菌H抗原有兩相,第一相為特異性抗原,用a、b、c……表示;第二相為共同抗原,用1、2、3……表示。
(3)表面抗原:已證實沙門菌屬有Vi、M和5抗原三種。Vi抗原加熱60℃30min或經石炭酸處理被破壞,其存在時可阻止0抗原與相應抗體發生凝集。
5.變異性
(1)S-R變異,菌落光滑型經人工培養傳代後逐漸變成粗糙型。此時菌體表面的特異多糖抗原喪失,在生理鹽水中可出現自凝。
(2)H-O變異,指有鞭毛的沙門菌失去鞭毛的變異。
(3)相位變異,具有雙相H抗原(第I相為特異相,第Ⅱ相為非特異相)的沙門菌變成只有其中某一相H抗原的單相菌,稱相位變異。
(4)V-W變異,失去全部Vi抗原的變異。
(二)致病性
致病因素有侵襲力、內毒素和腸毒素3種。臨床上可引起胃腸炎、腸熱症、菌血症或敗血症等。其中腸熱症屬法定傳染病。
1.腸熱症:即傷寒與副傷寒病。由傷寒與副傷寒沙門菌所引起的慢性發熱症狀。為法定傳染病之一。
2.食物中毒:引起食物中毒的沙門菌以鼠傷寒、腸炎、湯卜遜、豬霍亂、乙型及丙型副傷寒沙門菌為常見。
3.慢性腸炎:沙門菌可引起老人和兒童的慢性腸炎。
4.敗血症:多由豬霍亂沙門菌引起。
5.沙門菌的局部感染如頸部、腰部等。
有鼠傷寒沙門菌引起兒童的醫院感染報導。
(三)微生物學檢查
1.標本採集:根據不同疾病採取不同的標本進行分離與培養。腸熱症的第一、二周採血液,第二、三周采糞便與尿液。整個病程中骨髓分離細菌陽性率較高。食物中毒採集食物與糞便。
2.檢查方法及鑑定
(1)分離培養
1)糞便:一般將糞便或肛拭直接接種於SS和麥康凱平板上,用兩種培養基的目的是為提高標本的陽性檢出率。
2)血液和骨髓:抽取患者血液5ml或骨髓0.5ml,立即接種於含0.5%膽鹽肉湯或葡萄糖肉湯5ml試管中進行增菌,48h將培養物移種到血平板和腸道鑑別培養基上,若有細菌生長取菌塗片革蘭染色並報告結果。對增菌培養物連續培養7天,仍無細菌生長時,則報告陰性。
3)尿液:取尿液2~3ml經硫磺酸鹽肉湯增菌後,再接種於腸道菌選擇培養基或血平板上進行分離培養,亦可將尿液離心沉澱物分離培養。
4)局部感染的膿液。
(2)鑑定:沙門菌屬的鑑定與志賀菌屬相同,須根據生化反應和血清學鑑定兩方面進行。
1)初步鑑定:如為革蘭陰性桿菌時作氧化酶試驗,陰性時,挑取可疑菌落分別移種於KIA和MIU上。並作生化反應。以沙門菌多價診斷血清作玻片凝集試驗。
凡符合KIA:K/A、產氣+/-、H2S+/-、MIU:動力+、吲哚-、脲酶-,氧化酶-,觸酶+,硝酸鹽還原+,以沙門菌多價血清作玻片凝集試驗陽性,鑑定為沙門菌屬。
2)最後鑑定:沙門菌血清學鑑定主要藉助於沙門菌O抗原多價血清與O、H、Vi抗原的單價因子血清。甲型副傷寒沙門菌、鼠傷寒沙門菌和傷寒沙門菌分別屬於A、B、D血清群。
(3)血清學診斷:肥達試驗:用已知的傷寒沙門菌0、H抗原,甲乙丙副傷寒沙門菌H抗原稀釋後與被檢血清作定量凝集試驗,以檢測患者血清中抗體的含量,來判斷機體是否受沙門菌感染而導致腸熱症並判別沙門菌的種類。
(四)防治原則
加強飲食衛生,防止污染食品及水源經口感染,攜帶者的積極治療,皮下注射死菌苗或口服減毒活菌苗是預防沙門菌屬細菌傳染的幾個主要措施。臨床治療是根據體外藥敏試驗結果選用合適抗生素,保持水及電解質的平衡,對併發症積極處理,如腸出血、腸穿孔、膽囊炎、心肌炎等。對於傷寒沙門菌感染,可選擇的抗生素有氯黴素、氟喹諾酮類、氨苄西林、複方新諾明、三代頭孢等。
相關詞條
-
其他沙門菌感染
其他沙門菌感染是由各種沙門菌(Salmonellae)所引起的急性傳染病。
流行病學 病因 發病機制 臨床表現 診斷 -
沙門菌屬感染
沙門氏菌屬的分類主要以抗原結構為依據。 描述沙門菌屬感染系指各種沙門菌所致的急性傳染病。 感染了乙型副傷寒桿菌的病人,不常發生皮疹,若有發疹則分布較廣泛...
概述 症狀體徵 治療方案 -
沙門菌感染
要特別注意詢問有無家庭及管理人員通過飲食管理或生活接觸造成被傳染沙門菌的可能。 疾病概述 沙門菌感染是由各種沙門菌所引起的急性傳染病。沙門菌屬...疾病名稱沙門菌感染沙門菌感染疾病分類感染科 疾病病因起病當日至2周前...
疾病概述 症狀體徵 診斷檢查 治療方案 安全提示 -
沙門菌食物中毒
沙門菌屬種類繁多,目前國際上已發現2300多個血清型,我國有255個.其中引起食物中毒的主要有鼠傷寒沙門菌,豬霍亂沙門菌,腸炎沙門菌等.沙門菌進入腸道後...
流行病學特點 病原學特點 中毒表現 預防措施 -
沙門代菌
沙門氏菌病的病原體。 沙門氏桿菌的h抗原有兩種,稱為第1相和第2相。 每一組沙門氏桿菌根據h抗原不同,可進一步分種或型。
-
霉漿菌屬
假如鴿蛋只感染霉漿菌屬,小鴿會被孵出,可是它從第一天就被感染。 霉漿菌屬幾乎是以連續的基礎存在鴿子的體內,不需要從外界因為疾病爆發而感染。 治療從病鴿完...
簡介 傳染 傷害 症狀 治療 -
立刻菌星
立刻菌星抗菌作用與慶大黴素基本相似,對腸桿菌科細菌如大腸桿菌、克雷伯菌屬、腸桿菌屬、變形桿菌屬、志賀菌屬、沙門菌屬、枸椽酸桿菌屬、沙雷菌屬、綠膿桿菌、硝...
藥物名稱 藥理作用 動力學 適應症 用法用量 -
腐敗菌
食物的敗壞,主要是由於微生物中的腐敗菌、病菌搗亂的結果。愈是營養價值高的食品,它們就越愛鑽營繁衍。許多味美可口的菜餚和食物,一經腐敗菌和病菌光顧。不消幾...
基本信息 常見種類 污染途徑 危害 腐敗注意事項 -
遲鈍愛德華菌
遲鈍愛德華氏菌 (Edwardsiellatarda)是目前在水產養殖中有極大危害的病原菌 ,它是由Hoshina (1 96 2a) 首次報導 ,與日...
特性 危害 致病性 檢驗方法 血清學分型